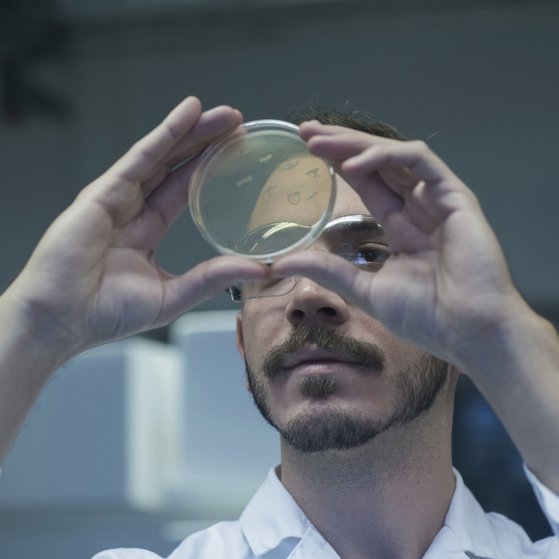
Mikrobielle Risiken Männliche Person im weißen Kittel hält Petrischale in die Höhe und schaut sich Ager an.

Bewertung mikrobieller Risiken von Lebensmitteln
Eine der zentralen Aufgaben des BfRkurz fürBundesinstitut für Risikobewertung ist die Bewertung mikrobieller Risiken von Lebensmitteln.
Unsere Themen zu mikrobiellen Risiken
Salmonellen, Listerien, Campylobacter – und andere Bakterien sowie Viren in Lebensmitteln können zur Gesundheitsgefahr für den Menschen werden. Aufgabe des BfRkurz fürBundesinstitut für Risikobewertung ist es, die Verbreitungswege dieser mikrobiellen Risiken in der Lebensmittelkette zu bekämpfen und das gesundheitliche Risiko belasteter Lebensmittel und Futtermittel zu bewerten. Die Bekämpfung von Erregern setzt dabei so früh wie möglich an: bei der Lebensmittelgewinnung und Herstellung.
Lebensmittelbedingte Erkrankungen durch Mikroorganismen
Mikroorganismen sind - abgesehen von Fehlernährung - die mit Abstand häufigste Ursache für lebensmittelbedingte Erkrankungen. Krankheitserreger können in Lebensmitteln, die vom Tier stammen, aber auch in pflanzlichen Lebensmitteln vorkommen. Die heute wichtigsten Lebensmittelinfektionen, die Campylobacteriose und Salmonellose, nehmen ihren Ursprung überwiegend in der Urproduktion, also in den Tierbeständen.
Fragen und Antworten zu mikrobiellen Risiken
Erforschung von Salmonelleninfektionen und anderen Zoonosen
Krankheiten, die vom Tier auf den Menschen übergehen können, bezeichnet man als Zoonosen. Von Bedeutung sind hier z.B. die mit Lebensmitteln übertragbaren Listerien, Toxoplasmen und Yersinien.
Aufgaben der BfRkurz fürBundesinstitut für Risikobewertung-Experten sind die Erforschung von Zoonose-Erregern, ihrer Übertragungs- und Verbreitungswege sowie die Entwicklung von Diagnosemethoden, die für Routineuntersuchungen bei Lebensmitteln geeignet sind.
Eine Salmonellose ist eine von Salmonellen (Bakterien) verursachte entzündliche Erkrankung des Magen-Darm-Traktes (infektiöse Gastroenteritis). Diese wird durch mangelnde Hygienemaßnahmen, durch den Genuss belasteten Trinkwassers bzw. den Verzehr kontaminierter Lebensmittel verursacht.
Campylobacteriose wiederum bezeichnet Erkrankungen, die durch Bakterien der Gattung Campylobacter, eine Gattung korkenzieherförmiger Bakterien, verursacht werden.
Video: Was sind Zoonosen?
Referenzlaboratorien für Zoonoseerreger
Zur Bekämpfung der bedeutendsten Zoonoseerreger entwickelt das BfRkurz fürBundesinstitut für Risikobewertung Maßnahmen für eine nachhaltig sichere Lebensmittelproduktion.
Am BfRkurz fürBundesinstitut für Risikobewertung sind hierfür zusätzliche nationale Referenzlaboratorien für verschiedene Zoonoseerreger angesiedelt, um die sehr hohen Anforderungen bei der Sicherung des gesundheitlichen Verbraucherschutzes zu erfüllen.
